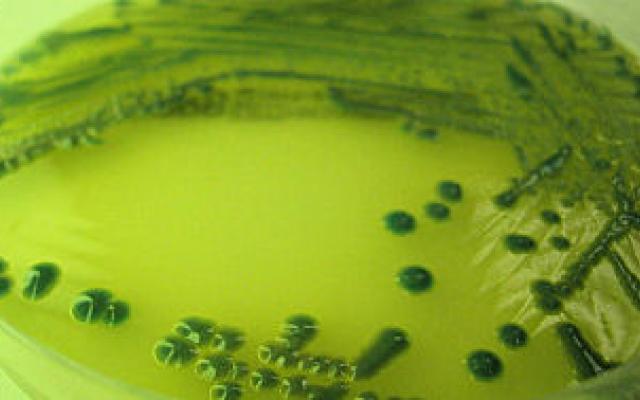

Stimulerende maatregelen voor de National Institutes of Health. – Voortzetting van het onderzoeksprogramma binnen de muren van de National Institutes of Health (NIH) te Bethesda, USA, komt in gevaar door de moeilijkheid wetenschappelijke werkers van hoge kwaliteit aan te trekken (JAMA 1989; 261: 344). In de laatste vijf jaar hebben…
Artikelinformatie
Online verschenen op
Citeer dit artikel als
Ned Tijdschr Geneeskd. 1989;133:419

Reacties